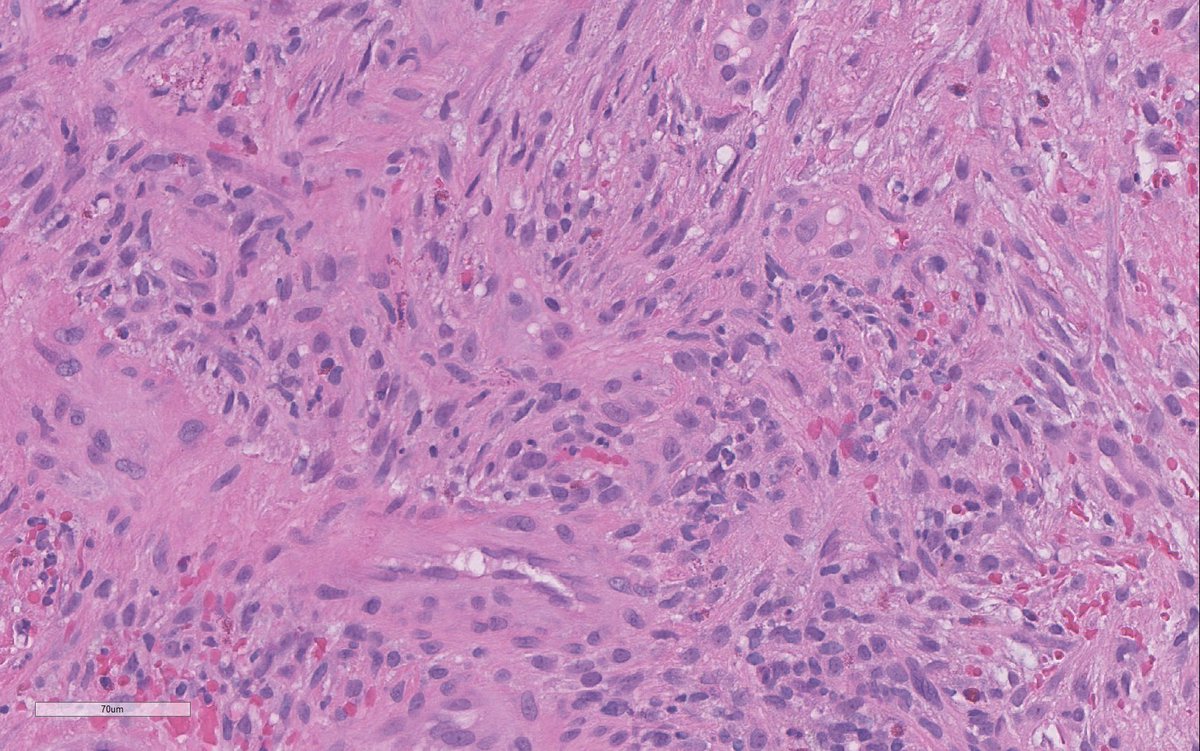
Ilan Weinreb 🇮🇱🇨🇦 אילן וינרב tweet media

@JLHornick @TBrennster Deepest condolences. A true doyen of pathology, he will be so missed.
English
Sangeetha N Kalimuthu
69 posts

@SNKali
GI/Pancreas/Soft Tissue Pathologist, University Health Network, Toronto, inveterate morphologist, ardent admirer of the spoken word, pudding fancier




Happy to share our work with @OwkinScience on a daring challenge: Can #PDAC epithelial and stromal molecular phenotypes be identified from standard histology slides? Better yet, can this help resolve intra-tumor heterogeneity? a thread 🧵 nature.com/articles/s4146…